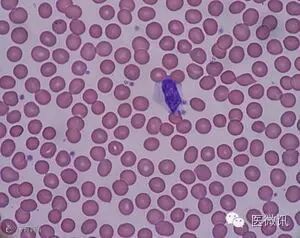

先上图:



《爱丽丝梦游仙境》里,爱丽丝变成动物大小,世界已经变得如童话般精彩。
如果可以变得更小,进入到人体里看,会是怎样的呢?这种视角也许只有造物主看到过哦。
高倍显微镜下,看到的血液是这样的。
(大量显现红血细胞;中央有1个的细胞是白细胞;红血细胞之间看上去像小碎片一样的东西是血小板。)
今天,我们的3D动画师,结合技术与美学,再加上大胆的想象力,已经将“进入人体”这一视角变为“现实”。

这样唯美的微观世界是如何做出来的呢?【视频】
(以下是分步骤渲染的单帧图片,可以看到相互叠加后呈现的效果。)
1.红细胞暖光

2.红细胞冷光

3.红细胞方向光

4.冷暖光合成

5.三种光的合成

6.红细胞固有色

7.红细胞sss材质

8.红细胞合成

9.红细胞冷暖色合成

10.红细胞外光

11.红细胞外光合成

12.病毒

13.病毒内部

14.病毒合成

15.病毒外光合成

16.红细胞和病毒的合成

17.高光层

18.细胞高光合成

19.景深通道

20.前景实体后景透明效果

21.前景实体后景模糊效果

22.背景

23.背景和前景合成

24.不同色调的合成

25.突出重点的压脚

26.冷暖矫色

27.对比矫正

THE END

备注:文中部分图片源自网络,如有侵权,请联系我们,谢谢。

